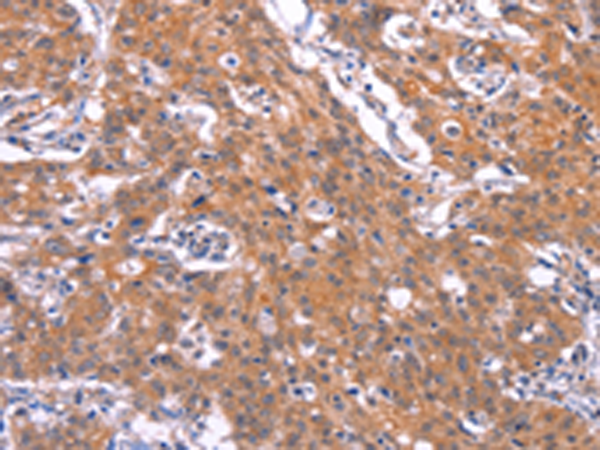

|
Background: |
The protein encoded by this gene is a member of the TNF-receptor superfamily. This receptor is preferentially expressed in mature B lymphocytes, and may be important for B cell development and autoimmune response. This receptor has been shown to specifically bind to the tumor necrosis factor (ligand) superfamily, member 13b (TNFSF13B/TALL-1/BAFF), and to lead to NF-kappaB and MAPK8/JNK activation. This receptor also binds to various TRAF family members, and thus may transduce signals for cell survival and proliferation |
|
Applications: |
ELISA, WB, IHC |
|
Name of antibody: |
TNFRSF17 |
|
Immunogen: |
Synthetic peptide of human TNFRSF17 |
|
Full name: |
tumor necrosis factor receptor superfamily, member 17 |
|
Synonyms: |
BCM; BCMA; CD269; TNFRSF13A |
|
SwissProt: |
Q02223 |
|
IHC positive control: |
Human gastric cancer and human liver cancer |
|
IHC Recommend dilution: |
50-200 |
|
WB Predicted band size: |
20 kDa |
|
WB Positive control: |
Mouse skeletal muscle tissue |
|
WB Recommended dilution: |
200-1000 |
購物車
幫助
021-54845833/15800441009
